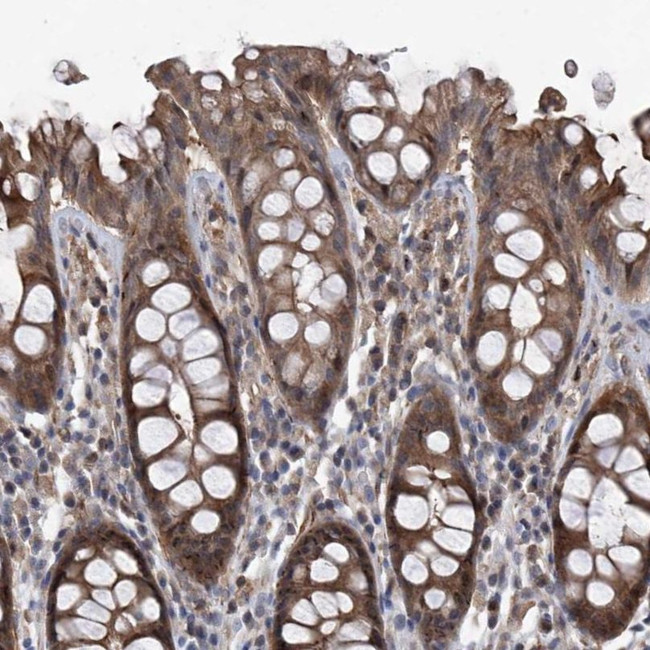
NT5C3A Antibody in Immunohistochemistry (IHC)

Search
Invitrogen
NT5C3A Polyclonal Antibody
{{$productOrderCtrl.translations['antibody.pdp.commerceCard.promotion.promotions']}}
{{$productOrderCtrl.translations['antibody.pdp.commerceCard.promotion.viewpromo']}}
{{$productOrderCtrl.translations['antibody.pdp.commerceCard.promotion.promocode']}}: {{promo.promoCode}} {{promo.promoTitle}} {{promo.promoDescription}}. {{$productOrderCtrl.translations['antibody.pdp.commerceCard.promotion.learnmore']}}
产品信息
PA5-56052
种属反应
宿主/亚型
分类
类型
抗原
偶联物
形式
浓度
规格
纯化类型
保存液
内含物
保存条件
运输条件
RRID
产品详细信息
Immunogen sequence: RIKNPTRVEE IICGLIKGGA AKLQIITDFD MTLSRFSYKG KRCPTCHNII DNCKLVTDEC RKKLLQLKEK YYAIEVDPVL TVEEKYPYMV EWYTKSHGLL VQQALPKAKL KEIVAESDVM LKEGY
Highest antigen sequence identity to the following orthologs: Mouse - 93%, Rat - 93%.
靶标信息
Pyrimidine 5-prime-nucleotidase (P5N), also called uridine 5-prime monophosphate hydrolase (UMPH), catalyzes the dephosphorylation of the pyrimidine 5-prime monophosphates UMP and CMP to the corresponding nucleosides. There are 2 isozymes of pyrimidine 5-prime nucleotidase in red blood cells, referred to as type I (UMPH1) and type II (UMPH2). The 2 enzymes are not separable by electrophoresis in humans but have distinct kinetic properties, and the proteins show no homology.
仅用于科研。不用于诊断过程。未经明确授权不得转售。
篇参考文献 (0)
生物信息学
蛋白别名: 5'-nucleotidase, cytosolic III; 7-methylguanosine nucleotidase; 7-methylguanosine phosphate-specific 5'-nucleotidase; cN-III; Cytosolic 5'-nucleotidase 3; Cytosolic 5'-nucleotidase 3A; Cytosolic 5'-nucleotidase III; lupin; MGC27337; MGC87109; MGC87828; NT5C3; p36; P5'N-1; Pyrimidine 5'-nucleotidase 1; unnamed protein product; Uridine 5'-monophosphate hydrolase 1
基因别名: cN-III; CNSHA8; HSPC233; hUMP1; NT5C3; NT5C3A; p36; P5'N-1; P5N-1; P5N1; PN-I; POMP; PSN1; UMPH; UMPH1
UniProt ID: (Human) Q9H0P0
Entrez Gene ID: (Human) 51251